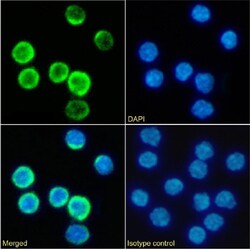
Invitrogen CD25 Chimeric Recombinant Rabbit Monoclonal Antibody (PC-61.5.3)

Learn More
Invitrogen™ CD25 Chimeric Recombinant Rabbit Monoclonal Antibody (PC-61.5.3)


Description
Specificity: This antibody is specific for murine CD25, the 55 kDa interleukin-2 receptor alpha chain (IL-2R alpha). CD25 is expressed by early progenitors of the T and B lineage as well as by activated mature T and B lymphocytes. By itself, CD25 binds IL-2 only with low affinity. However, CD25 associates with CD122 (IL-2 receptor beta chain) and CD132 (common gamma chain) to form the high affinity IL-2 receptor. Binding of IL-2 to both the high and low affinity classes of IL-2 receptor is inhibited by the PC61.5 antibody.

Specifications
Specifications
| Antigen | CD25 Chimeric |
| Applications | ELISA, Flow Cytometry, Functional Assay, Western Blot, Immunocytochemistry |
| Classification | Recombinant Monoclonal |
| Clone | PC-61.5.3 |
| Concentration | 1 mg/mL |
| Conjugate | Unconjugated |
| Formulation | PBS with 0.02% ProClin 300 |
| Gene | IL2RA |
| Gene Accession No. | P01590 |
| Gene Alias | ADA; ADA1; Adenosine aminohydrolase; adenosine deaminase; CD25; CD25 antigen; cytokine receptor; IDDM10; IL 2 RA; IL 2 receptor; IL 2R; IL 2R subunit alpha; IL2 RA; IL2 RA antibody; IL2 receptor; il-2 receptor alpha; IL-2 Receptor alpha chain; IL-2 receptor alpha subunit; IL2 receptor subunit alpha; IL-2 receptor subunit alpha; IL2R; IL-2R alpha; IL-2R alpha chain; IL2R subunit alpha; IL-2R subunit alpha; Il2ra; IL-2RA; IL-2-RA; IL2-RA; Il2ra antibody; IL2RAC; IMD41; interleukin 2 receptor; interleukin 2 receptor alpha chain; interleukin 2 receptor subunit alpha; interleukin 2 receptor, alpha; interleukin 2 receptor, alpha chain; interleukin-2 receptor alpha; interleukin-2 receptor alpha chain; interleukin-2 receptor alpha subunit; interleukin-2 receptor beta chain; Interleukin2 receptor subunit alpha; interleukin-2 receptor subunit alpha; Ly-43; p55; p55 chain; sIL 2R; soluble IL 2 receptor; TAC antigen; TCGFR |
| Show More |
By clicking Submit, you acknowledge that you may be contacted by Fisher Scientific in regards to the feedback you have provided in this form. We will not share your information for any other purposes. All contact information provided shall also be maintained in accordance with our Privacy Policy.